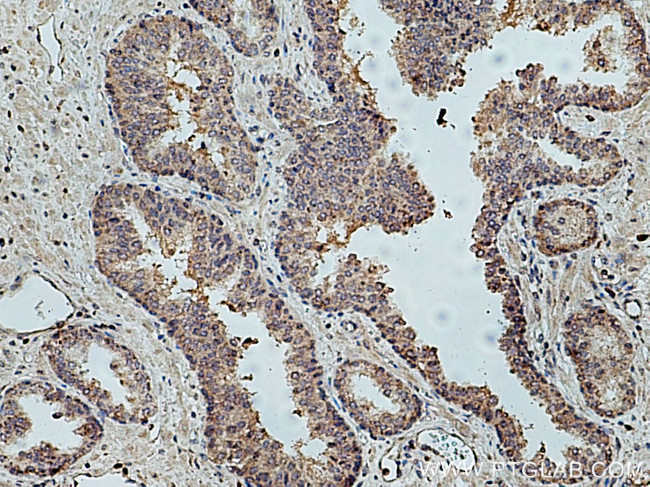
KIF14 Antibody in Immunohistochemistry (Paraffin) (IHC (P))

Search
Proteintech
KIF14 Polyclonal Antibody
{{$productOrderCtrl.translations['antibody.pdp.commerceCard.promotion.promotions']}}
{{$productOrderCtrl.translations['antibody.pdp.commerceCard.promotion.viewpromo']}}
{{$productOrderCtrl.translations['antibody.pdp.commerceCard.promotion.promocode']}}: {{promo.promoCode}} {{promo.promoTitle}} {{promo.promoDescription}}. {{$productOrderCtrl.translations['antibody.pdp.commerceCard.promotion.learnmore']}}
产品信息
26000-1-AP
种属反应
宿主/亚型
分类
类型
抗原
偶联物
形式
浓度
规格
纯化类型
保存液
内含物
保存条件
运输条件
产品详细信息
Immunogen sequence: SDRAIQSLT IQTACAFEQL VVLMKHWLSD LLPCTNIARL EDELRQEVKK LGGYLQLFLQ GCCLDISSMI KEAQKNAIQI VQQAVKYVGQ LAVLKGSKLH FLENGNNKAA SVQEEFMDAV CDGVGLGMKI LLDSGLEKAK ELQHELFRQC TKNEVTKEMK TNAMGLIRSL ENIFAESKIK SFRRQVQEEN FEYQDFKRMV NRAPEFLKLK HCLEKAIEII ISALKGCHSD INLLQTCVES IRNLASDFYS DFSVPSTSVG SYESRVTHIV HQELESLAKS LLFCFESEES PDLLKPWETY NQNTKEEHQQ SKSSGIDGSK NKGVPKRVYE LHGSSAAVSS EECTPSRIQW V (1299-1648 aa encoded by BC113742)
靶标信息
This gene encodes a member of the kinesin-3 superfamily of microtubule motor proteins. These proteins are involved in numerous processes including vesicle transport, chromosome segregation, mitotic spindle formation, and cytokinesis. In human HeLa-S3 and 293T cells, this protein is localized to the cytoplasm during interphase, to the spindle poles and spindle microtubules during mitosis, and to the midbody during cytokinesis. An internal motor domain displays microtubule-dependent ATPase activity, consistent with its function as a microtubule motor protein. Knockdown of this gene results in failed cytokinesis with endoreplication, which results in multinucleated cells. This gene has been identified as a likely oncogene in breast, lung and ovarian cancers, as well as retinoblastomas and gliomas. Alternative splicing results in multiple transcript variants.
仅用于科研。不用于诊断过程。未经明确授权不得转售。
篇参考文献 (0)
生物信息学
蛋白别名: epididymis secretory sperm binding protein; KIAA0042; Kinesin-like protein KIF14
基因别名: KIAA0042; KIF14; MCPH20; MKS12
UniProt ID: (Human) Q15058
Entrez Gene ID: (Human) 9928